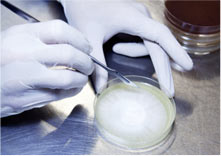
Newsletter

Einsatz von Trametes versicolor
bei HPV und CIN I
Eine Studie von Dr. J. Silva Couto zeigt durch den Einsatz von Trametes versicolor (aka. Coriolus versicolor) eine Verbesserung bei CIN I (Zervikale Intraepitheliale Neoplasie). Trametes versicolor steigert auch die Regressionsrate von Hochrisiko-HPV-Stämmen.
Mykorrhiza steigert Wachstum,
Nährstoffaufname und Salztoleranz von Oliven
Der Olivenbaum (Olea europaea) gilt als sehr robust und anspruchslos. Doch die zunehmende Versalzung von Ackerland reduziert Wachstum und Ernteerträge. Durch die Hitze verdunstet die Feuchtigkeit aus dem Boden, was zurückbleibt, sind Mineralien. Die gezielte Beimpfung von Olivenbäumen mit Mykorrhiza kann die negativen Effekte auf die Pflanze umkehren. Mit Mykorrhiza wird das Wurzelwachstum um mehr als 400 % gesteigert.